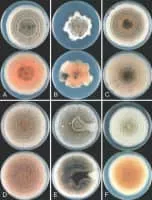
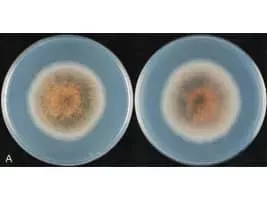

Colletotrichum
| Use attributes for filter ! | |
| Class | Sordariomycetes |
|---|---|
| Scientific name | Colletotrichum |
| Kingdom | Fungi |
| Higher classification | Glomerellaceae |
| Order | Glomerellales |
| Rank | Genus |
| Date of Reg. | |
| Date of Upd. | |
| ID | 2468198 |
About Colletotrichum
Colletotrichum is a genus of fungi that are symbionts to plants as endophytes or phytopathogens. Many of the species in this genus are plant pathogens, but some species may have a mutualistic relationship with hosts.